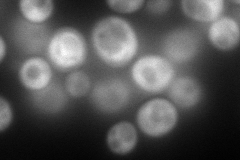
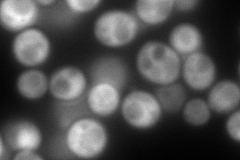
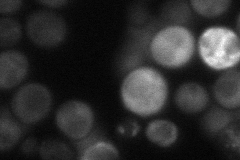
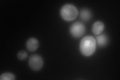

View description
ATP sulfurylase, catalyzes the primary step of intracellular sulfate activation, essential for assimilatory reduction of sulfate to sulfide, involved in methionine metabolism
Localization:
Intensity:
Fold change:
Significance:
-
C’ GFP library in SD

cytosol75.91 -
N' NOP1pr-GFP in SD
cytosol239.533 -
N' TEF2pr-mCherry in SD
cytosol246.195 -
N' NATIVEpr-GFP in SD
cytosol36.6855 -
N' TEF2pr-VC and Cyto-VN in SD

cytosol85.1791 -
C’ GFP library in SD+DTT

cytosol213.622.81Yes -
C’ GFP library in SD+H2O2

cytosol209.232.75Yes -
C’ GFP library in Starvation Media
nucleusN/AN/AYes -
C’ GFP library on the background of Pup2-DaMP

cytosol -
C’ GFP library on the background of CCT mutant

cytosol143.8511.89485Yes
